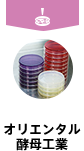
oriental

株式会社
日清製粉グループ本社
総務本部 人事部長
様々な仕事に携わり、
経験を自らの力に変えてほしい。
創業120年余を数える日清製粉グループが、ここまで事業を続けてこられたのは、社是の一つである「時代への適合」、つまり、時代のニーズに合わせた施策を先取りして打ち続けてきたからだと考えています。少子化等による国内需要の縮小、高齢化や働く女性の増加など、食を取り巻く環境は大きく変化していますが、現在は長期ビジョン「NNI“Compass for the Future”」に基づき、成長戦略を推進しています。「企業は変化することによってのみ生存が可能となり、かつ発展を望み得る」との認識の下、日清製粉グループは10年後、20年後の社会全体の構造変化を見据えて、挑戦を続けていきます。
継続的な挑戦を支えてきた当社グループの「人」の力。その人物像を言葉にすると大きく3点が挙げられます。1点目は「信頼を大切にする人」。「自分1人が儲けることを考えると事業はけっして長続きしない。すなわち信は万事の本である」という創業者の言葉が「信を万事の本と為す」というもう一つの社是となっています。「信」とは信用・信頼のこと。今でも全社員がこの言葉を念頭に、様々な事業活動に携わっていますが、自らを繕わず、物事に正面から、真摯に取り組み、周囲の信頼を得ることは当社での活躍のベースです。2点目は「ボーダーレスに行動する人」。物事の全体像を俯瞰したうえで、自らの組織の枠に捉われず、経験や考えが違う人の意見もよく理解し、周囲に積極的に働きかけられる人です。例えば、パンという一つの食材を取っても小麦粉、ミックス、イーストなど当社の素材が様々な形で関わります。それぞれの部門の社員が、組織の枠を越え、お客様に価値ある商品を提供しようと取り組んでいます。「素材の力をお客様に活かしてもらいたい」、その想いが立場や組織を越え行動できる力を生み出していると思います。3点目は「自分の考え・想いを周囲に浸透できる人」。他人事や批評家的な態度ではなく、物事を自分事として捉え、自らの考え・想いを熱意を持って伝え、周りを巻き込んでいく力は施策を推進するために不可欠です。
私は日清製粉グループ本社、日清製粉、日清製粉ウェルナと3社にまたがって仕事をしてきました。中国での会社の立ち上げ等、各種のプロジェクトにも数多く参加する機会がありました。優秀な先輩方の指導をもらいながら、それらの仕事が自身の糧となり、社会人として成長できたのは間違いありません。皆さんにも、様々な仕事に携わり、経験を重ねることで立派な社会人に成長していただきたいと思います。努力の方向性を間違えなければ、日清製粉グループは、努力が必ず報われる良い会社だと思っています。皆さんにも「ここなら自分を成長させられそうだ」と思って入社してもらえると嬉しい限りです。
製粉業界のリーディングカンパニーである日清製粉グループでは、多種多様なお客様に小麦粉を安定供給する使命感を持って、日々の製造販売に取り組んでいます。また、私たちが扱っているパスタやお好み焼粉、から揚げ粉は誰しも食卓で目にしたことがあると思います。他にもパン作りには欠かせない酵母(イースト)や健康食品など、「食」に関わる土台を支えているのが日清製粉グループです。社会に対する影響力と安定した「食」を守るという使命、やりがいが皆さんを待っています。

日清製粉グループは、小麦粉製品やパスタ関連でトップシェアの商品を多く持っています。安全・安心へのこだわりは負けない自信があり、事業ごとに扱う商品は違えど、自社商品の品質管理は業界トップレベルと言っても過言ではありません。技術力と安全・安心な商品を武器に、お客様に自信を持って提案しています。営業担当者にとって「何を売るか」以上に「どんな気持ちで提案するか」は仕事を行ううえでの大きなモチベーションになってくるはずです。

日清製粉グループでは長期ビジョン「NNI“Compass for the Future”」を策定し、海外事業の展開に重点的に取り組んでいます。海外事業場の増加に伴い、そこでチャレンジするフィールドはどんどん広がっています。経験を積んだのち、海外子会社のマネジメントに関わったり、海外企業のM&Aに関わったりする社員もいます。柔軟な思考とチャレンジ精神のある社員は若いうちから海外事業を担当しており、海外へ挑戦したいと思っている熱い皆さんをお待ちしています。

小麦粉を小袋に詰めて売り出したのも、ミートソースやお好み焼粉を全国の家庭に広めたのも、つけ麺ブームの火付け役となったのも、日清製粉グループです。近年では「早ゆでスパゲティ」の市場を確立しています。まだ世の中に存在しないものや、より付加価値の高いものを生み出そうという全社を挙げての挑戦心とそれを具現化するための技術力、そしてお客様や世の中への提案力が私たちの持ち味です。次のヒット商品、新しい食のブームを私たちと一緒に作り上げていきませんか。

1年目の社員でも、社外のお客様に接する際は「日清製粉グループの窓口」となってそのブランドを背負うことになります。最初はお客様からの期待や信頼が自分の実力以上に大きくなり、戸惑うこともあるかもしれません。しかし、皆さんにとっては大きなチャンスです。日清製粉グループでは若いうちから、やる気がある社員には大きな仕事を任せる風土があります。困難に直面したら相談に乗ってくれる先輩社員がいますし、失敗すればフォローもしてくれます。「自分で考え行動し、経験しないと本当の実力は育たない」100年以上にわたって先輩たちが築き上げてきた伝統の中で、大きな志と大きな人間性を育てていきます。